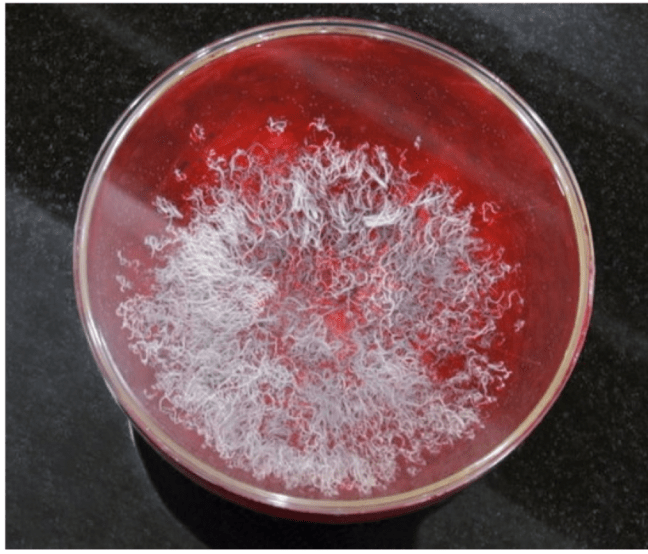
眾人在現場看到佛陀降下甘露穿過房頂和水晶缽蓋進入缽中。 眾人在現場看到佛陀降下甘露穿過房頂和水晶缽蓋進入缽中。

第三世多杰羌佛 沒有到場修法,但由於佛陀所說《藉心經說真諦》經典所在處,由寶書之無量功德佛力,感召了佛降甘露,一切無上殊勝的聖蹟,徹底證明了H.H. 第三世多杰羌佛 說法《藉心經說真諦》是最至高無上解脫成就的佛典經藏……往下閱讀全文)

「藉心經說真諦」
至寶經典法會 意外出現佛降甘露恭賀
(新聞來源:國際佛教僧尼總會)
文/洛杉磯訊
《藉心經說真諦》實在是至高無上殊勝的經典,此寶書於2014年陽曆3月7日,在美國聖蹟寺首度舉行加持法會,在法台上供奉了《藉心經說真諦》經典寶書,及由七眾行人唸誦修持的六部大法及聖咒和文書法水、楊枝等,前方存放了46枚準備法水加持的《藉心經說真諦》首發式印章。祿東贊慈仁嘉措法王把他親自從H.H. 第三世多杰羌佛 那裡請到的紫金銅缽,護送到了聖蹟寺,存放在精美堅固、花崗石雕成的祈福台上,由老法王祿東贊和八十多歲的開初仁波切及二十歲的貢嘎仁波切主持法會主角修法,祿東贊法王把缽親自交到開初仁波切手中,經祈禱後,浴沐壇城,再由貢嘎活佛打上清水,當眾洗缽,奉上祈福台,此次參會者全都是仁波切、法師、阿闍黎,大家十分虔誠地開始進入了唸誦六字大明咒和心經。
法會開始大概十幾分鐘,空中突然狂風捲起,呼嘯鳴響,諸聖護法駕臨,但掛在帷壁上的黃幡緞布,竟然沒有吹捲,此時弟子們各自看到了不同的聖境,殊勝無法言喻!待到經咒停下來時,貢嘎仁波切正準備將六杯法水匯入中央缽中時,他突然穿過透明缽蓋看到缽內出現光芒,定睛一看,原來缽內竟然有非常多的甘露,此時驚喜之外,納頭便拜,頃刻會場一片喜樂之境,各自紛紛進到缽前恭看,有人看到是五彩色,有人看到是紫紅色,有人看到是白色,形體非人間物相,美妙玄提!大家驚喜讚嘆,經過一陣心情喜樂歡嘆,最後六杯法水終於匯入甘露,成為甘露領銜的七支聖水,祿東贊法王將楊枝澆上聖水,灑在首發式印章,加持印泥、印章,並敲響紫金銅缽,以表法音傳遍天際法界,利益六道眾生,福慧圓滿。雖然H.H. 第三世多杰羌佛 沒有到場修法,但由於佛陀所說《藉心經說真諦》經典所在處,由寶書之無量功德佛力,感召了佛降甘露,一切無上殊勝的聖蹟,徹底證明了H.H. 第三世多杰羌佛 說法《藉心經說真諦》是最至高無上解脫成就的佛典經藏!

雖然H.H. 第三世多杰羌佛 未親自主法修持,但是祂在把缽交給祿東贊法王時說:「我不參加你們的法會了,我相信十方諸佛會加持你們法會的,因為《藉心經說真諦》是最至高無上圓滿的寶書,它會感召加持。」

另外特地告知大家,此法缽於2014年3月23日將會駕臨香港法會,敲響鳴聲為大家祈禱祝福,並與H.H. 第三世多杰羌佛 2012年返老回春時的對比照片,一併供奉在聖物室中供大家瞻仰法喜。
轉載自:「藉心經說真音」至寶經典法會意外出現佛降甘露恭賀|ETtoday國際新聞|ETtoday新聞雲|2014年3月11日報導
#多杰羌佛 #第三世多杰羌佛 #南無第三世多杰羌佛 #藉心經說真諦 #南無第三世多杰羌佛說法podcast #正法聯盟
相關文章鏈接:
